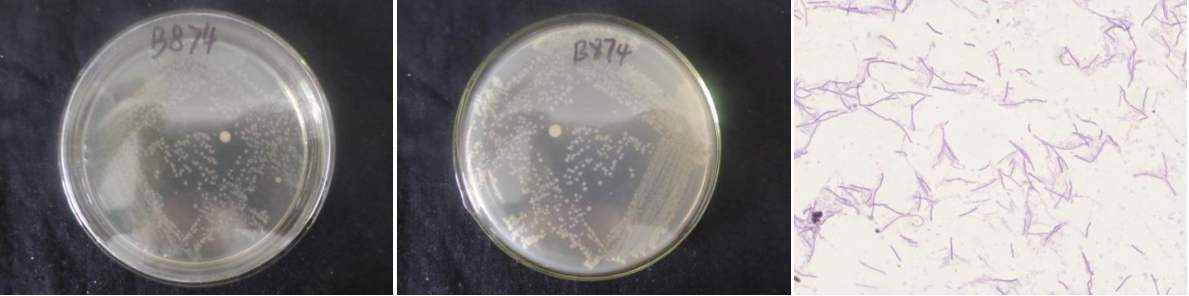

Loading...
| StrainNO | B874 |
| Classification | Bacillus |
| 16s rDNA sequence | CTATACATGCAAGTCGAGCGAATCTGAGGGAGCTTGCTCCCAAAGATTAGCGGCGGACGGGTGAGTAACACGTGGGTAACCTGC CTGTAAGATTGGGATAACTCCGGGAAACCGGAGCTAATACCGGATAACATTTCGAACCGCATGGTTCGAAATTGAAAGACGGCT TCGGCTGTCACTTACAGATGGACCCGCGGCGCATTAGCTAGTTGGTGAGGTAACGGCTCACCAAGGCGACGATGCGTAGCCGAC CTGAGAGGGTGATCGGCCACACTGGGACTGAGACACGGCCCAGACTCCTACGGGAGGCAGCAGTAGGGAATCTTCCGCAATGGA CGAAAGTCTGACGGAGCAACGCCGCGTGAACGATGAAGGCCTTCGGGTCGTAAAGTTCTGTTGTTAGGGAAGAACAAGTACCAG AGTAACTGCTGGTACCTTGACGGTACCTAACCAGAAAGCCACGGCTAACTACGTGCCAGCAGCCGCGGTAATACGTAGGTGGCA AGCGTTGTCCGGAATTATTGGGCGTAAAGCGCGCGCAGGCGGTTTCTTAAGTCTGATGTGAAAGCCCACGGCTCAACCGTGGAG GGTCATTGGAAACTGGGAAACTTGAGTGCAGAAGAGGAGAGTGGAATTCCACGTGTAGCGGTGAAATGCGTAGAGATGTGGAGG AACACCAGTGGCGAAGGCGACTCTCTGGTCTGTAACTGACGCTGAGGCGCGAAAGCGTGGGGAGCGAACAGGATTAGATACCCT GGTAGTCCACGCCGTAAACGATGAGTGCTAAGTGTTAGAGGGTTTCCGCCCTTTAGTGCTGCAGCAAACGCATTAAGCACTCCG CCTGGGGAGTACGGTCGCAAGACTGAAACTCAAAGGAATTGACGGGGGCCCGCACAAGCGGTGGAGCATGTGGTTTAATTCGAA GCAACGCGAAGAACCTTACCAGGTCTTGACATCCTTCGCTACTTCTAGAGATAGAAGGTTCCCCTTCGGGGGACGAAGTGACAG GTGGTGCATGGTTGTCGTCAGCTCGTGTCGTGAGATGTTGGGTTAAGTCCCGCAACGAGCGCAACCCTTGATCTTAGTTGCCAG CATTCAGTTGGGCACTCTAAGGTGACTGCCGGTGACAAACCGGAGGAAGGTGGGGATGACGTCAAATCATCATGCCCCTTATGA CCTGGGCTACACACGTGCTACAATGGATGGTACAAAGGGCTGCAAGACTGCGAAGTCAAGCCAATCCCATAAAACCATTCTCAG TTCGGATTGCAGGCTGCAACTCGCCTGCATGAAGCCGGAATCGCTAGTAATCGCGGATCAGCATGCCGCGGTGAATACGTTCCC GGGCCTTGTACACACCGCCCGTCACACCACGAGAGTTTGTAACACCCGAAGTCGGTGGGGTAACCGTAAGGAGCCAG |
| Strain Morphology Photos | |
| Morphological Description | Colony round;milk white;edge serrated;slippy;sticky;waxy;translucent;strain:Rod;having spore |